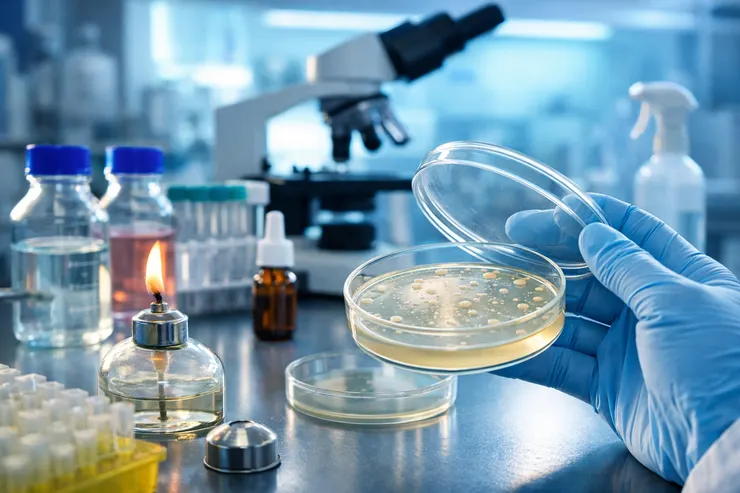
vocus｜新世代的創作平台

疫情那幾年,我第一次發現,原來這麼多人開始在意「細菌」這件事。
大家會搶酒精、噴消毒水、討論99.9%殺菌。電視廣告裡的畫面總是很乾淨,噴霧一出現,細菌就像動畫一樣瞬間消失。
但我每次看到那些畫面,都會想起以前在生醫材料實驗室工作的日子。
因為在實驗室裡,我們從來不假設細菌會消失。
我們只是假設它們一直都在。
空氣裡有、桌面上有、我們的袖口有。 甚至我們剛洗好的手上,還是有。
那時候我剛進實驗室,最困惑的一件事就是:
既然細菌到處都是,那所謂的「無菌」,到底怎麼可能做到的?
後來我慢慢理解,無菌不是魔法,而是精細的控制。
而那些常常在市面上看到的詞,其實代表的是完全不同的強度。
滅菌,是最乾脆的一種態度
實驗室裡只要能丟進高壓蒸氣滅菌鍋的東西,我們幾乎不會猶豫。
121°C,高壓,時間到。
滅菌的意思其實很直接殺死所有微生物,包括最頑強的孢子。
那是一種接近「清零」的概念。
不是99%,不是99.9%,而是把存活機率壓低到百萬分之一以下,相當於99.9999%。
在生醫材料研發裡,有些東西必須是這個等級。
因為材料最終可能接觸細胞,甚至進入人體。
那時候我才知道,「乾淨」其實有很多種。
消毒,是把風險降下來
酒精屬於消毒。
75%酒精可以殺死多數細菌與病毒,但對孢子效果有限。
疫情期間我們每天做的,其實大多是消毒。
降低感染風險,但不是把世界歸零。
消毒的核心不是「完全消失」,而是把危險降到安全範圍。
這是一種風險管理,而不是潔癖。
99.9%到底代表什麼?
這個數字很常出現在市面產品上。
99.9%聽起來幾乎是全部,但如果換一個方式說它代表的是 10³ 等級的減少。
也就是原本如果有一千個細菌,最後剩下一個。
在大多數日常環境裡,這已經是非常有效的抗菌能力。
例如銀離子材料的抗菌效果,也是可以維持一定時間的99.9%抑制率。
那其實是一個足夠用的強度。
不是把細菌世界消滅,而是讓它難以存活與繁殖。
當我第一次真正理解這個比例時,我突然明白很多時候,我們需要的不是「全部殺光」,
而是讓細菌無法成為問題。
抗菌與抑菌,其實是更溫和的控制
在生醫材料領域,很多時候我們不追求滅菌強度。
我們希望材料本身能「抗菌」,也就是破壞細菌結構,降低附著與繁殖能力。
或是「抑菌」,讓細菌無法快速增生,這是一種長期管理,就像在實驗室裡,我們知道空氣永遠不是無菌的。
但穩定氣流可以阻止落塵進入樣本。 器具經過滅菌。 手部經過消毒。 操作避免讓手跨過開口上方。做這些不是因為完全的乾淨,而是因為每個步驟都把風險壓低了一點。
防腐,則是關於細菌數量的時間管理
防腐不是為了讓東西變成無菌,而是防止微生物在產品中繁殖。
讓細菌即使存在,也難以擴張,它處理的是時間,而不是瞬間。
那無菌真的很難嗎?
如果你把無菌理解成「世界上沒有細菌」,那很難。
但如果你理解成:
在一個充滿微生物的環境中,透過滅菌、消毒、抗菌與抑菌的層層控制, 把風險壓低到可接受的程度,那它其實是一種理性的工程思維。
在實驗室裡,我學到的不是如何對抗細菌,而是如何理解它們。
知道什麼時候需要滅菌。
什麼時候消毒就夠。
什麼時候抗菌材料能提供長期保護。 什麼時候99.9%已經足夠安全。
疫情讓大家開始重視細菌。
但真正的安全,不是恐慌,而是知道自己正在使用的是哪一種層級。
細菌一直都在,無菌不是消失,而是管理。
而當我們理解這些差異之後,那些看起來抽象的名詞, 就不再只是廣告上的字眼了。